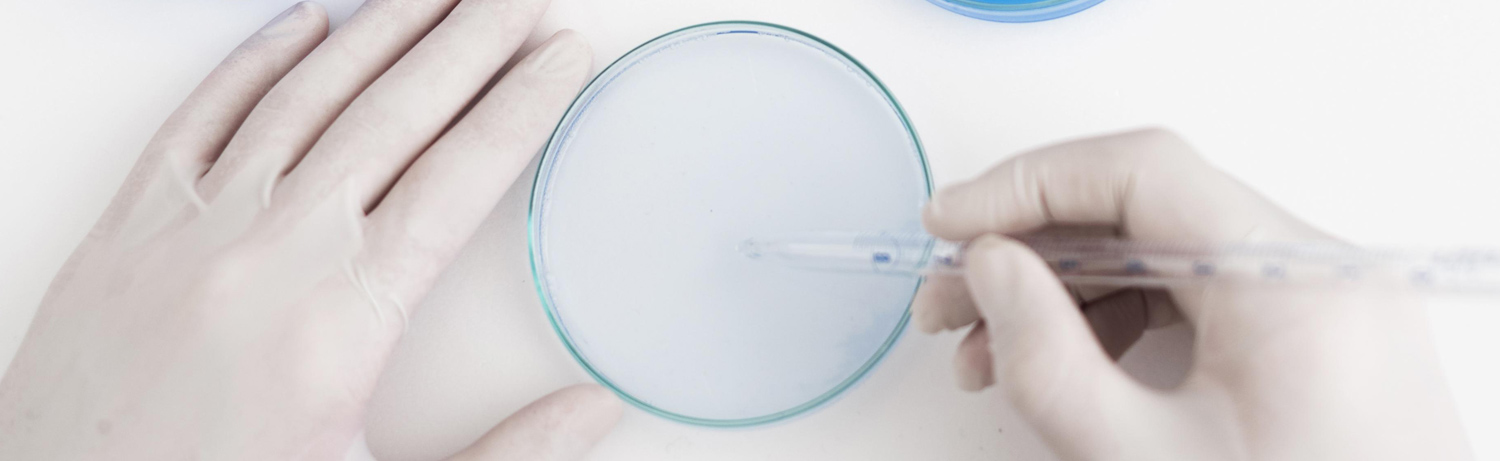

BFF olarak kalite politikamız, şirketin hedefleri doğrultusunda faaliyet göstermek ve aşağıdaki temel prensipleri ortak sorumluluk olarak hayata geçirmek.
Amacımız;
Hizmet verdiğimiz sağlık, güzellik, kozmetik ve ev bakım ürünlerinde, girişimci, gelişime odaklanmış, yeniliklere açık, kaliteden ödün vermeyen, kurumsallaşmış firma yapısına sahip olmak,
Uluslararası standartlar ve mevzuat koşulları ile uyumlu bir kalite yönetim sisteminin, BFF ’nin amaç ve hedefleri doğrultusunda etkin olarak kullanılmasını sağlamak ve sürekli geliştirmek,
Toplam kalite yönetimi düşüncesi ile sistemlerimizi ve süreçlerimizi müşteri beklentilerini de esas alarak sürekli iyileştirmek. Müşteri odaklı hizmet, kurumsal-toplumsal sorumluluk anlayışı, kurum içinde ve dışında güvenilir ve saygın ilişkiler kurmak, lider olmak ve geleceği kurgulamak,
Etkin yönetim, iletişim ve eğitim olanaklarından yararlanan çalışanların bilinçli katılımı ile tüm ürün ve hizmetlerde müşteri ihtiyaçlarına üstün kalite, gününde teslimat ve uygun fiyatla cevap vermek ve sürdürebilmek,
Teknolojiyi yakından takip ederek uygulamak ve müşteri memnuniyetini her zaman ilk hedef olarak almak,
İş ve kaynak yönetiminde süreç odaklı bakış açısı ile sürekli gelişme hedeflerini yaygın katılımla gerçekleştirmek
Kalite politikamızdır.
Belgeyi indirinBFF; işletmesindeki tüm çalışanlarını en önemli değer kabul ederek, onlara uygun sağlıklı ve güvenli iş ortamı sağlamayı, aldığı önlemlerle iş kazası ve iş hastalıklarını bertaraf etmeyi amaç edinmiştir.
Bu amaç doğrultusunda;
İSG Yönetim Sistemini; ulusal kanun ve yönetmelikler, uluslararası yükümlülükler, üyesi olunan ulusal ve uluslararası kuruluşların şartları, şartname gerekleri, müşteri ve diğer paydaşlarının beklentileri doğrultusunda uygun dokümantasyonu oluşturarak, yapılandıracaktır.
İSG Yönetim Sisteminin işletimi için, üst yönetim tarafından her türlü kaynak tahsis edilerek, çalışanlarımızı ve birlikte çalışılan taşeron ve tedarikçi elemanlarını eğitimlerle bilinçlendirecektir.
Tüm çalışanların; İSG Yönetim Sisteminin gerektirdiği uygun ekipman/teçhizatı kullanarak, ilgili prosedür ve talimatlara göre sorumluluklarının bilincinde ve çevreye zarar vermeyecek şekilde faaliyetlerini yürütmeleri sağlanacaktır.
Tüm çalışanların katılımıyla; uygun iş ortamını sağlayarak, işçi sağlığı ve iş güvenliğine yönelik riskleri en aza indirmeyi hedefler ve yönetim sistemimizi geliştirerek sürekliliğini sağlayacaktır.
Belgeyi indirinBFF olarak çevre politikamız, şirketin hedefleri doğrultusunda faaliyet göstermek ve aşağıdaki temel prensipleri ortak sorumluluk olarak hayata geçirmek.
Amacımız BFF faaliyet alanı ve hizmet metotları yönünden çevreye zarar vermeden, çevreyle dost şekilde çalışmak,
Dünyamızın kısıtlı kaynaklarının verimli olarak kullanılmasının ve çevre konusundaki sorumlulukların bilincinde olmak,
Çevre ile ilgili yasal mevzuatlara ve düzenlemelere uymak,
Atıklarımızı; olanaklarımızın müsaade ettiği ölçüler içerisinde azaltarak, çevreye en az zarar verecek şekilde bertaraf etmek,
Doğal kaynakların kullanımını azaltarak, geri dönüşümlü malzemelerin kullanımına özen göstermek,
Faaliyetlerimizde ve yeni yatırımlarımızda, çevre faktörünü dikkate almak,
Çevresel performansımız, ISO 14001 Çevre Yönetim Sistemi’ ne paralel olarak sürekli geliştirilerek kirliliği önlemek,
Çalışanlarımızı, müşterilerimizi ve tedarikçilerimizi çevre konusunda bilinçlendirmek
Çevre Politikamızdır.
Belgeyi indirin.png)